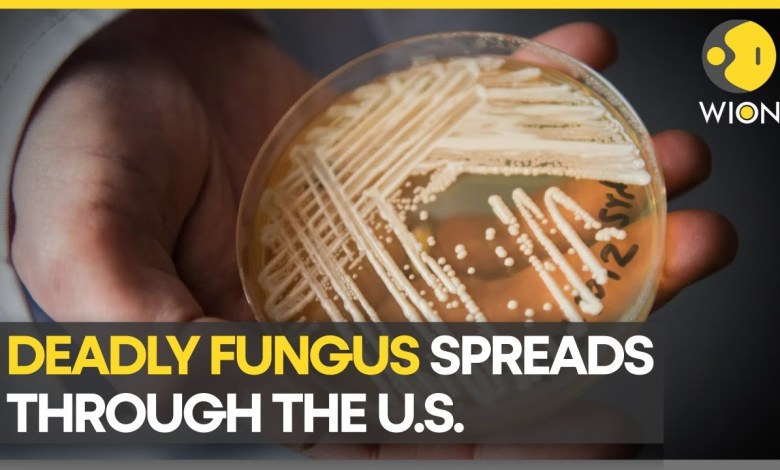
Berichte: Der Pilz CANDIDA AURIS hat in den USA mindestens 2.377 Menschen infiziert | Neueste Weltnachrichten | WION Berichte: Der Pilz CANDIDA AURIS hat in den USA mindestens 2.377 Menschen infiziert | Neueste Weltnachrichten | WION

Neue Studie: Essbare Pilze könnten bei der Regulierung von Blutzucker helfen Laut einer neuen Studie der Semmelweis-Universität können essbare Pilze…
Weiterlesen »Pilze
Tragischer Vorfall: Mutter stirbt nach Pilzvergiftung Karaman: Am vergangenen Dienstag, den 31. Oktober, sammelte die Familie Yarınınözü Pilze in einem…
Weiterlesen »